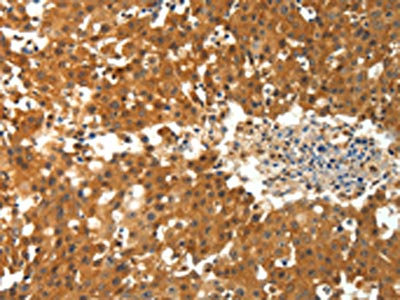

PTPRE Antibody
-
中文名稱:PTPRE兔多克隆抗體
-
貨號:CSB-PA832569
-
規格:¥1100
-
圖片:
-
The image on the left is immunohistochemistry of paraffin-embedded Human breast cancer tissue using CSB-PA832569(PTPRE Antibody) at dilution 1/10, on the right is treated with fusion protein. (Original magnification: ×200)
-
The image on the left is immunohistochemistry of paraffin-embedded Human lung cancer tissue using CSB-PA832569(PTPRE Antibody) at dilution 1/10, on the right is treated with fusion protein. (Original magnification: ×200)
-
-
其他:
產品詳情
-
Uniprot No.:
-
基因名:PTPRE
-
別名:PTPRE; Receptor-type tyrosine-protein phosphatase epsilon; Protein-tyrosine phosphatase epsilon; R-PTP-epsilon
-
宿主:Rabbit
-
反應種屬:Human,Mouse,Rat
-
免疫原:Fusion protein of Human PTPRE
-
免疫原種屬:Homo sapiens (Human)
-
標記方式:Non-conjugated
-
抗體亞型:IgG
-
純化方式:Antigen affinity purification
-
濃度:It differs from different batches. Please contact us to confirm it.
-
保存緩沖液:-20°C, pH7.4 PBS, 0.05% NaN3, 40% Glycerol
-
產品提供形式:Liquid
-
應用范圍:ELISA,IHC
-
推薦稀釋比:
Application Recommended Dilution ELISA 1:1000-1:5000 IHC 1:15-1:50 -
Protocols:
-
儲存條件:Upon receipt, store at -20°C or -80°C. Avoid repeated freeze.
-
貨期:Basically, we can dispatch the products out in 1-3 working days after receiving your orders. Delivery time maybe differs from different purchasing way or location, please kindly consult your local distributors for specific delivery time.
-
用途:For Research Use Only. Not for use in diagnostic or therapeutic procedures.
相關產品
靶點詳情
-
功能:Isoform 1 plays a critical role in signaling transduction pathways and phosphoprotein network topology in red blood cells. May play a role in osteoclast formation and function.; Isoform 2 acts as a negative regulator of insulin receptor (IR) signaling in skeletal muscle. Regulates insulin-induced tyrosine phosphorylation of insulin receptor (IR) and insulin receptor substrate 1 (IRS-1), phosphorylation of protein kinase B and glycogen synthase kinase-3 and insulin induced stimulation of glucose uptake.; Isoform 1 and isoform 2 act as a negative regulator of FceRI-mediated signal transduction leading to cytokine production and degranulation, most likely by acting at the level of SYK to affect downstream events such as phosphorylation of SLP76 and LAT and mobilization of Ca(2+).
-
基因功能參考文獻:
- these data demonstrate that HCV infection reduces PTPRE expression in the liver and peripheral blood mononuclear cell sof infected humans PMID: 28235043
- Studies indicate that RAD50 and PTPRE of crude associations with asthma at a Bonferroni-corrected level of significance, while IL4R, CCL5 and TBXA2R of nominal significance. PMID: 21734400
- Transfection of cells with different PTPepsilon constructs and activator protein-1 reporter gene indicates that the catalytic activity of PTPepsilon is involved in the regulation of the mitogen-activated protein kinase cascade. PMID: 12121439
- Characterization, expression and functional aspects of an alternative spliced isoform of protein tyrosine phosphatase epsilon PMID: 12193229
- Functions to prevent inappropriate activation and to terminate prolonged, rather than acute, activation of ERK in the cytosol. PMID: 12754301
- cyt-PTP epsilon is dimerized and phosphorylated in the absence of direct interaction between the PTP and extracellular molecules PMID: 12861030
- Transgenic mice overexpressing catalytically inactive transmembrane protein tyrosine phosphatase epsilon provide unexpected insight into the cell-cell interactions that occur between oligodendrocytes and the cells which they myelinate. PMID: 15390114
- Protein-tyrosine phosphatase epsilon regulates Shc signaling in a kinase-specific manner: increasing coherence in tyrosine phosphatase signaling PMID: 18093973
顯示更多
收起更多
-
亞細胞定位:[Isoform 1]: Cell membrane; Single-pass type I membrane protein.; [Isoform 2]: Cytoplasm.; [Isoform 3]: Cytoplasm.
-
蛋白家族:Protein-tyrosine phosphatase family, Receptor class 4 subfamily
-
組織特異性:Expressed in giant cell tumor (osteoclastoma rich in multinucleated osteoclastic cells).
-
數據庫鏈接:
Most popular with customers
-
-
YWHAB Recombinant Monoclonal Antibody
Applications: ELISA, WB, IHC, IF, FC
Species Reactivity: Human, Mouse, Rat
-
Phospho-YAP1 (S127) Recombinant Monoclonal Antibody
Applications: ELISA, WB, IHC
Species Reactivity: Human
-
-
-
-
-